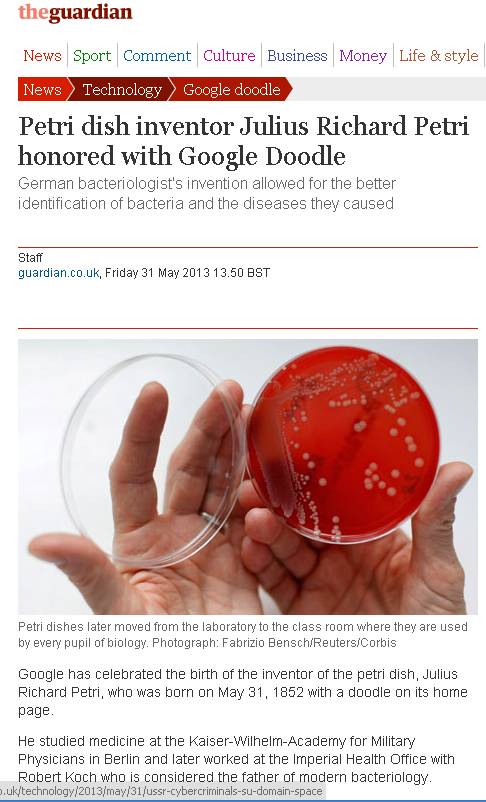

Haberler »




- Dernek
- Yeterlik Kurulu
- Çalışma Grupları
- Çalışma Grupları Yönergesi
- Tüberküloz
- Antibiyotik Direnci
- İnfeksiyon İmmunolojisi
- Viral Hepatit
- Diyabetik Ayak İnfeksiyonları
- Sağlık Bakımıyla İlişkili İnfeksiyonlar
- Erişkin Bağışıklaması
- HIV/AIDS
- İnfektif Endokardit
- İnsan Mikrobiyom ve Biyoterapi
- Mantar İnfeksiyonları
- Nakil İnfeksiyonları
- Cinsel Yolla Bulaşan İnfeksiyonlar
- Paraziter İnfeksiyonlar
- Antimikrobiyal Yönetişimi
- Zoonotik İnfeksiyonlar Çalışma Grubu
- AGUH Komisyonu
- KLİMİK Mobil Geliştirme Grubu
- Toplantılar
- Yayınlar
- Klimik Uygulamalar